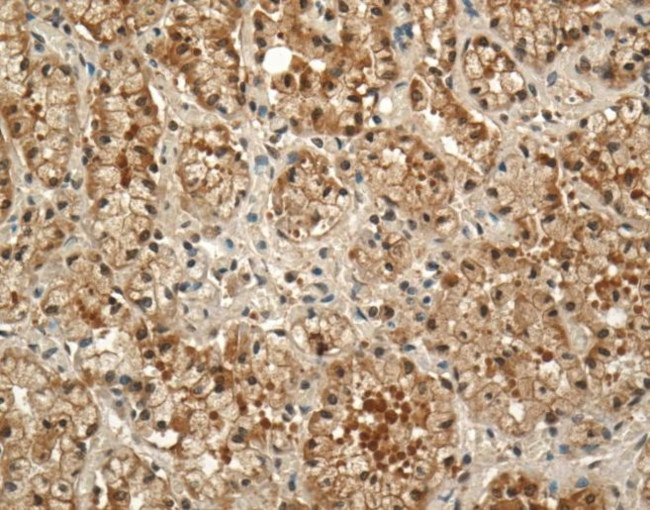
Prolactin Receptor Antibody in Immunohistochemistry (IHC)

Search
Invitrogen
Prolactin Receptor Monoclonal Antibody (U5)
{{$productOrderCtrl.translations['antibody.pdp.commerceCard.promotion.promotions']}}
{{$productOrderCtrl.translations['antibody.pdp.commerceCard.promotion.viewpromo']}}
{{$productOrderCtrl.translations['antibody.pdp.commerceCard.promotion.promocode']}}: {{promo.promoCode}} {{promo.promoTitle}} {{promo.promoDescription}}. {{$productOrderCtrl.translations['antibody.pdp.commerceCard.promotion.learnmore']}}
图: 1 / 11
Prolactin Receptor Antibody (MA1-610) in IHC











Please note: We are reviewing Western blot images included in the antibody testing data in our catalog, including those provided by third parties. Unless expressly labeled or annotated as “raw-unedited”, Western blot images included in the antibody testing data in our catalog may have been edited, optimized or otherwise adjusted for presentation.
产品信息
MA1-610
种属反应
已发表种属
宿主/亚型
分类
类型
克隆号
抗原
偶联物
形式
浓度
规格
纯化类型
保存液
内含物
保存条件
运输条件
RRID
产品详细信息
MA1-610 detects prolactin (PRL) receptor from rat, human, rabbit, horse, and pig tissues.
MA1-610 has been successfully used in Western blot, immunohistochemistry, immunocytochemistry, immunoprecipitation, immunofluorescence, and FACS procedures. By Western blot, this antibody detects an ~40 kDa protein and an ~100 kDa protein representing both the short and long forms of the PRL receptor, respectively, in various tissues. Immunohistochemical staining of PRL receptor in rat Islets of Langerhans with MA1-610 results in a staining pattern consistent with cytoplasmic vesicle staining. MA1-610, after biotinylation, has been used to detect human lymphocyte PRL receptor by FACS. MA1-610 does not inhibit the interaction of prolactin with the receptor.
The MA1-610 immunogen is purified PRL receptor from rat liver. This antibody has been shown to react with the extracellular portion of the receptor, but not in the ligand binding domain. MA1-610 does not inhibit the interaction of prolactin with the receptor.
Reconstitute with 100 µL PBS.
靶标信息
Prolactin (PRL) is a pituitary hormone involved in the stimulation of milk production, salt and water regulation, growth, development and reproduction. PRL exerts its influence on different cell types through a signal transduction pathway which begins with the binding of the hormone to a transmembrane PRL receptor. Immunoreactive PRL receptor (PRLR), a member of the cytokine receptor family, varies in size (short and long forms) with tissue source and species, from ~40 kDa to 100 kDa. PRLR consists of at least three separate domains: an extracellular region with 5 cysteines which contains the prolactin binding site, a single transmembrane domain and a cytoplasmic region, the length of which appears to influence ligand binding and regulate cellular function.
仅用于科研。不用于诊断过程。未经明确授权不得转售。
生物信息学
蛋白别名: cytokine receptor; Lactogen receptor; Prl R; PRL-R; Prolactin receptor; prolactin receptor 2 precursor; prolactin receptor related sequence 1; prolactin receptor short isoform
基因别名: AI987712; pPRLR-SF; Pr-1; Pr-3; PRLR; Prlr-rs1; RATPRLR
UniProt ID: (Rabbit) P14787, (Pig) Q6JTA8, (Rat) P05710, (Mouse) Q08501
Entrez Gene ID: (Rabbit) 100009046, (Pig) 414916, (Horse) 100053793, (Rat) 24684, (Mouse) 19116